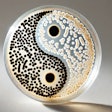
Dall·e 2024 10 28 15 31 36 A Close Up Image Of A Petri Dish With A Yin Yang Symbol Inside, Made From Colonies Of Light And Dark Bifidobacterium Bacteria The Bacteria Form Disti

Tim Wall covers the dog, cat and other pet food industries as a senior reporter for WATT Global Media. He holds an M.A. in journalism and an M.S. in natural resources, both from the University of Missouri - Columbia, along with a bachelor's degree in biology. He is the author of "Carpe Eat'um: Invasive Carp Cookbook." Wall served in the Peace Corps in Honduras from 2005 to 2007, where he coordinated with the town government of Moroceli to organize a municipal trash collection system, taught environmental science, translated for medical brigades and facilitated regenerative agriculture, along with other projects.
Contact Wall via wattglobalmedia.com/contact-us